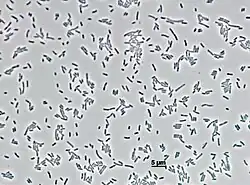

Solimicrobium
| Solimicrobium silvestre | ||
|---|---|---|
![]() | ||
| Taxonomía | ||
| Dominio: | Bacteria | |
| Reino: | Pseudomonadati | |
| Filo: | Pseudomonadota | |
| Clase: | Betaproteobacteria | |
| Orden: | Burkholderiales | |
| Familia: | Oxalobacteraceae | |
| Género: |
Solimicrobium Margesin et al. 2018 | |
| Especie: | Solimicrobium silvestre | |
Solimicrobium es un género de bacterias gramnegativas de la familia Oxalobacteraceae. Fue descrito en el año 2018. Actualmente (2024) solo contiene una especie Solimicrobium silvestre. Su etimología hace referencia a microbio del suelo. El nombre de la especie hace referencia a bosque.[1] Es aerobia y móvil. Tiene un tamaño de 0,8 μm de ancho por 1,7-2 μm de largo. Forma colonias circulares, convexas, de color amarillo pálido y con márgenes enteros en agar R2A. También crece en agar TSA. Temperatura de crecimiento entre 0-25 °C, óptima de 15-25 °C. Catalasa y oxidasa positivas. Tiene un genoma de 5,2 Mpb y un contenido de G+C de 46,7%. Se ha aislado del suelo de bosque alpino en el Tirol, Italia.
Referencias
- ↑ Margesin, Rosa; Albuquerque, Luciana; Zhang, De-Chao; Froufe, Hugo J. C.; Severino, Rita; Roxo, Inês; Egas, Conceição; da Costa, Milton S. (2018-08). «Solimicrobium silvestre gen. nov., sp. nov., isolated from alpine forest soil». International Journal of Systematic and Evolutionary Microbiology 68 (8): 2491-2498. ISSN 1466-5034. PMID 29939122. doi:10.1099/ijsem.0.002861. Consultado el 2 de marzo de 2023.